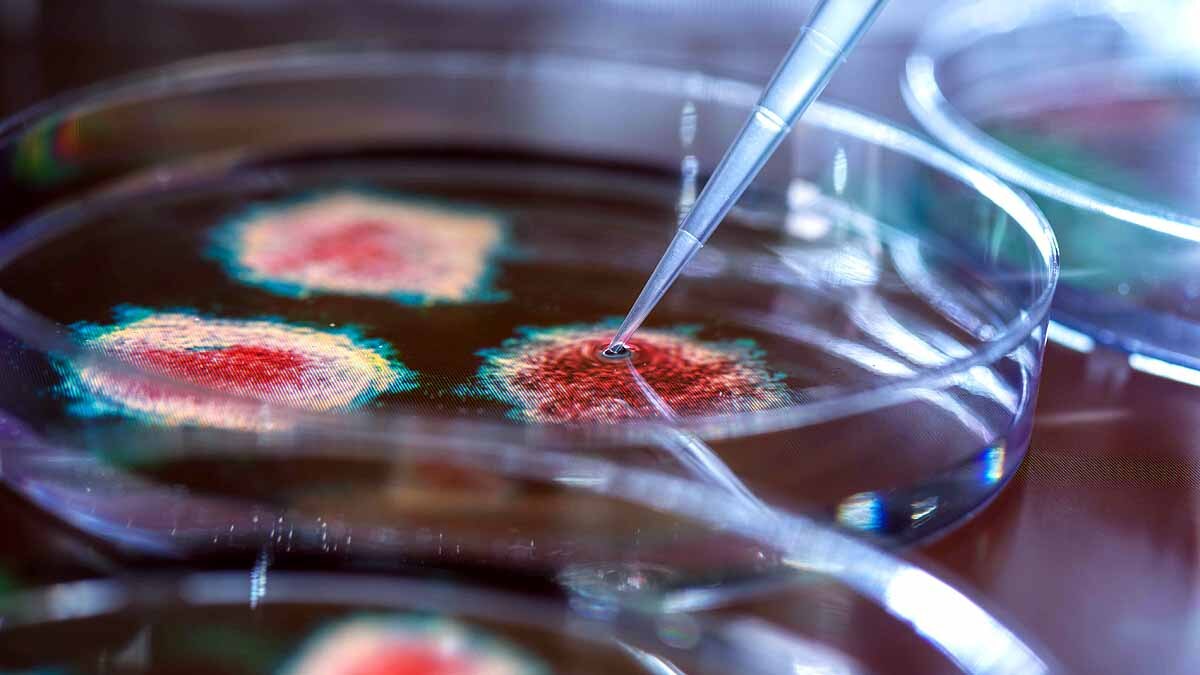
Covid-19 Attack Pancreas Diabetes

स्टडीः Covid-19 से हो सकता है डायबिटीज, ये है असली वजह
Covid-19 से डायबिटीज हो सकता है. एक नई स्टडी में यह बात सामने आई है. कोरोनावायरस पैंक्रियाज (Pancreas) यानी अग्नाशय पर हमला करता है. उसके अंदर इंसुलिन बनाने वाली कोशिकाओं को नष्ट कर देता है. इससे इंसान को डायबिटीज होने की आशंका बढ़ जाती है. पिछले साल बसंत के मौसम में न्यूयॉर्क शहर में जो लोग कोविड-19 से संक्रमित हुए, उनके खून में शुगर का लेवल बढ़ा हुआ मिला. जिसे हाइपरग्लाइसीमिया (Hyperglycemia) कहते हैं. यह डायबिटीज का शुरुआती लक्षण माना जाता है. (फोटोःगेटी)
वील कॉर्नेल मेडिसिन में स्टेम सेल बायोलॉजिस्ट शुईबिंग चेन ने कहा कि मेरी टीम ने देखा कि कोरोना से संक्रमित कुछ मरीजों के खून में शुगर का स्तर बढ़ा हुआ है. उन लोगों को भी यह दिक्कत आ रही थी, जिनकी मेडिकल हिस्ट्री में डायबिटीज का नामोनिशान नहीं था. ऐसे भी मरीज थे, जिन्हें कोरोना संक्रमण से पहले डायबिटीज नहीं था, लेकिन संक्रमण के बाद उन्हें डायबिटीज हो गया. ऐसा कोरोना संक्रमण से रिकवर होने के बाद हुआ. (फोटोःगेटी)
यह बात पूरी दुनिया को पता है कि कोरोना वायरस यानी SARS-CoV-2 सबसे ज्यादा नुकसान फेफड़ों और सांस लेने से संबंधित प्रणाली को पहुंचाता है. इससे एक्यूट रेस्पिरेटरी डिस्ट्रेस (Acute Respiratory Distress) होता है. लेकिन इसकी वजह डायबिटीज जैसी क्रॉनिक बीमारियां कैसे और क्यों हो रही हैं, यह अब भी वैज्ञानिकों और डॉक्टरों के लिए रहस्य है. कोरोना संक्रमण के बाद बहुत से लोगों को डायबिटीज की दिक्कत आ रही है. जबकि, उन्हें पहले यह समस्या नहीं थी. (फोटोःगेटी)
कनाडा के मैक्मास्टर यूनिवर्सिटी में पॉप्युलेशन हेल्थ रिसर्चर टी. सतीश कहते हैं कि उन्होंने पिछले साल एक स्टडी की थी. यह पूरी दुनिया में बीमार पड़े कोरोना मरीजों से संबंधित थी. उसमें सतीश ने देखा कि कोरोना संक्रमित लोगों में से करीब 15 प्रतिशत लोगों को संक्रमण के दौरान या उसके बाद डायबिटीज की दिक्कत हो गई. जिनका शुगर लेवल पहले से बॉर्डर लाइन पर था, उनके लिए डायबिटीज का खतरा संक्रमण के बाद ज्यादा हो गया. (फोटोःगेटी)
सतीश ने बताया कि हार्वर्ड मेडिकल स्कूल के एंडोक्राइनोलॉजिस्ट पाओलो फियोरिना ने इटली के अस्पताल में भर्ती 551 कोविड मरीजों की जांच की. इनमें से करीब आधे हाइपरग्लाइसीमिया से ग्रसित थे. स्टैनफोर्ड यूनिवर्सिटी स्कूल ऑफ मेडिसिन के बायोकेमिस्ट पीटर जैकसन कहते हैं कि कोरोना वायरस की वजह से गंभीर रूप से संक्रमित लोगो में से 30 प्रतिशत लोगों को डायबिटीज होने का खतरा रहता है. इसी का पता करने के लिए शुईबिंग चेन और पीटर जैकसन ने नई स्टडी की. (फोटोःगेटी)
चेन और जैकसन की स्टडी में इस बात का अध्ययन किया जा रहा था कि कैसे SARS-CoV-2 हाइपरग्लाइसीमिया को बढ़ाता है. इनकी रिपोर्ट Cell Metabolism के मई संस्करण में प्रकाशित हुई है. जॉन्स हॉपकिंस डिविजन ऑफ एंडोक्राइनोलॉजी, डायबिटीज और मेटाबॉलिज्म में मेडिसिन की एसोसिएट प्रोफेसर रीता कल्याणी ने बताया कि चेन और जैकसन की स्टडी से यह पता चलता है कि कैसे कोरोना वायरस हाइपरग्लाइसीमिया को बढ़ाकर लोगों को डायबिटीज का शिकार बना रहा है. यह स्टडी नए शोध का जरिया बन सकता है. (फोटोःगेटी)
कोरोना वायरस अलग-अलग लोगों के शरीर में अलग-अलग तरह से असर डालता है. जरूरी नहीं कि सभी को एक जैसी बीमारियां या दिक्कतें हों. कुछ लोगों को हल्के लक्षण दिखते हैं, कुछ में गंभीर. ये बात भी पुख्ता हो चुकी है कि यह वायरस सिर्फ फेफड़ों पर असर नहीं डालता. यह लिवर, किडनी, दिल, दिमाग, प्रजनन अंग आदि सब पर प्रभाव डालता है. अब यह बात भी पुख्ता हो चुकी है कि कोविड-19 से डायबिटीज और मोटापा भी बढ़ता है. (फोटोःगेटी)
चेन की स्टडी में यह बात स्पष्ट तौर पर पुख्ता हुई है कि अग्नाशय यानी पैंक्रियाज की बीटा कोशिकाएं कोरोना वायरस की जकड़ में आसानी से आ जाती है. अग्नाशय का काम खाने को पचाने के लिए सटीक मात्रा में रसायन निकालना होता है. यहीं पर बीटा कोशिकाएं होती हैं, जो इंसुलिन पैदा करती है. यही हॉर्मोन खून के अंदर शुगर के कणों को संतुलित रखता है. ताकि जरूरत पड़ने पर उन शुगर कणों को ऊर्जा देने में तब्दील किया जा सके. ये जांच तो चेन और जैकसन ने प्रयोशाला में की. इसके बाद उन्हें इसकी सच्चाई जानने के लिए कुछ अलग करना पड़ा. (फोटोःगेटी)
चेन और जैकसन ने कोविड-19 से मारे गए कुछ लोगों के शरीर का अटॉप्सी किया. पता चला कि इन मारे गए लोगों के अग्नाशय की बीटा कोशिकाओं में कोरोना वायरस मौजूद है. लेकिन हैरानी की बात ये थी कि आखिरकार फेफड़ों को संक्रमित करने वाला कोरोना वायरस कैसे अग्नाशय यानी पैंक्रियाज तक पहुंचा. आपको बताते हैं कैसे? जब इंसान को निमोनिया होता है, तब उसके फेफड़ों का निचला हिस्सा बुरी तरह से क्षतिग्रस्त हो जाता है. यानी वहां के टिश्यू मतलब ऊतक टूट जाते हैं. इसकी वजह से वायरस फेफड़ों से लीक करके शरीर के निचले हिस्से मे मौजूद अंगों तक खून की नसों के जरिए पहुंच जाते हैं. (फोटोःगेटी)
पीटर जैकसन कहते हैं कि एक बार यह वायरस फेफड़ों से निकलकर खून की नसों के जरिए शरीर के अन्य हिस्सों में पहुंचा तो समझिए शरीर में तबाही का मंजर शुरू होने वाला है. यह पैंक्रियाज, दिमाग और किडनी तक को खराब कर सकता है. अगर किसी व्यक्ति के आंतों में स्वस्थ बैक्टीरिया नहीं है तो यह वायरस उसके आंतों को भी बुरी तरह से प्रभावित कर सकता है. अगर स्वस्थ बैक्टीरिया है तो यह कोरोना वायरस से संघर्ष करके उसके हमले को कमजोर करते हैं. अब सवाल ये उठता है कि आखिर कोरोना वायरस इंसुलिन की उपज को खत्म कैसे करता है? (फोटोःगेटी)
जब कोरोना वायरस पैंक्रियाज की बीटा कोशिकाओं पर हमला करता है, तब ये कोशिकाएं खुद को खत्म कर लेती है. इस प्रक्रिया तो एपॉपटोसिस (Apoptosis) कहते हैं. यह प्रक्रिया जेनेटिकली प्रोग्राम्ड सेल्फ डिस्ट्रक्शन सिक्वेंस होता है. जैसे ही कोरोना वायरस का हमला होता है, उससे घायल बीटा कोशिकाएं सेल्फ डिस्ट्रक्शन को एक्टीवेट कर देती है. जिससे सारी बीटा कोशिकाएं मरने लगती है. इनके मरते ही इंसुलिन का उत्पादन शरीर में बंद हो जाता है. (फोटोःगेटी)
New studies show that the #COVID19 virus can attack the pancreas, destroy cells that make insulin, and cause some cases of diabetes https://t.co/kcEp14Y4nQ
— National Geographic (@NatGeo) June 13, 2021
चेन की स्टडी में ये बात सामने आई कि कुछ बीटा कोशिकाएं ट्रांसडिफरेंसिएशन (Transdifferentiation) की प्रक्रिया में चली जाती है. यानी ये कोशिकाएं खुद को अन्य तरह की कोशिकाओं में बदल लेती हैं, जिनसे इंसुलिन का उत्पादन नहीं होता. यानी कुछ बीटा कोशिकाएं खुद को बदल लेती हैं और कुछ खुद को मार देती हैं. दोनों ही स्थितियों में इंसुलिन का उत्पादन शरीर में बंद हो जाता है. इसकी वजह से टाइप-1 डायबिटीज होने का खतरा बढ़ जाता है. (फोटोःगेटी)
टाइप-1 डायबिटीज सामान्य बीमारी है. जिसके होने के बाद इंसान को हर दिन इंसुलिन का इंजेक्शन लेना पड़ता है. क्योंकि उनके शरीर में इंसुलिन बनना बंद हो जाता है. वहीं, टाइप-2 डायबिटीज तब होता है जब शरीर में बनने वाले इंसुलिन प्रभावी नहीं रहते. टाइप-2 डायबिटीज से संक्रमित लोगों का खान-पान बदलने, व्यायाम करने और कुछ दवाओं के सहारे ठीक किया जा सकता है. सीडीसी की रिपोर्ट के मुताबिक 2020 में 3.42 करोड़ अमेरिकी लोगों को डायबिटीज की शिकायत है. अब मुद्दा ये है कि कोविड-19 से होने वाली डायबिटीज की समस्या को ठीक कैसे किया जाए? (फोटोःगेटी)
इस स्टडी में चेन और जैकसन ने बताया कि कोरोना से होने वाली डायबिटीज को ठीक करने के लिए ट्रांस-आईएसआरआईबी (trans-ISRIB) की मदद ली जा सकती है. यह बीटा कोशिकाओं को उनका वजूद खत्म करने से रोकता है. साथ ही उनकी इंसुलिन पैदा करने की क्षमता को बनाए रखता है. trans-ISRIB का मतलब होता है इंटीग्रेटेड स्ट्रेस रेसपॉन्स इन्हिबिटर. इसे साल 2013 में खोजा गया था. यह बुरे वक्त में कोशिकाओं को उनका वजूद खोने से रोकता है. इससे बीटा कोशिकाएं एपॉपटोसिस की प्रक्रिया से बच जाती हैं. यानी खुद को खत्म कर नहीं पातीं. (फोटोःगेटी)
चेन ने बताया कि इसके साथ एक ही दिक्कत है कि trans-ISRIB को अमेरिका के FDA ने अभी इंसानों के उपयोग के लिए मंजूरी नहीं दी है. लेकिन हमारी स्टडी में यह बात स्पष्ट हुई है कि यह कोरोना वायरस से संक्रमित लोगों को डायबिटीज से बचा सकता है. साथ ही यह फायदा हो सकता है कि दुनियाभर के वैज्ञानिक और रिसर्चर एपॉपटोसिस को रोकने के लिए trans-ISRIB पर और अध्ययन कर सकते हैं. ताकि भविष्य में कोरोना संक्रमण के दौरान इंसानों को डायबिटीज से बचाया जा सके. (फोटोःगेटी)
चेन ने बताया कि सिर्फ कोरोना वायरस इकलौता ऐसा वायरस नहीं है जो पैंक्रियाज पर हमला करता है. इसके अलावा Coxsackievirus B, rotavirus, mumps virus और cytomegalovirus भी यही काम करते हैं. ये वायरस भी पैंक्रियाज की बीटा कोशिकाओं को निष्क्रिय या खत्म करने का काम करते हैं. हालांकि ये सीधे तौर पर टाइप-1 डायबिटीज की समस्या पैदा करते हैं या नहीं इस पर अब भी विवाद चल रहा है. लेकिन ये पैंक्रियाज पर असर डालते हैं, यह बात तो पुख्ता हो चुकी है. (फोटोःगेटी)
रीता कल्याणी कहता है कि कोरोना संक्रमण और पैंक्रियाज पर होने वाले इसके असर से बचने के लिए जरूरी है कि लोग जितनी जल्दी हो सके, वैक्सीन लगवा लें. जिन लोगों को पहले कोरोना संक्रमण हो चुका है या जिन्हें डायबिटीज की शिकायत पहले से है, वो इसकी जानकारी पहले ही अपने डॉक्टर को बताएं. ताकि संक्रमण के दौरान अगर हाइपग्लाइसीमिया के लक्षण दिखाई दें तो तुरंत इसका इलाज किया जा सके. हाइपरग्लाइसीमिया होने पर बार-बार पेशाब आता है. ज्यादा प्यास लगती है. आंखों के सामने धुंधला छा जाता है. साथ ही अप्रत्याशित तौर पर वजन कम हो जाता है. (फोटोःगेटी)